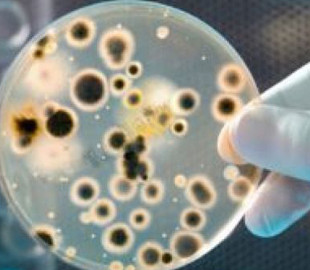
«Може призвести до смерті»: лікарі розповіли, чим небезпечна сибірка, яку нещодавно виявили на Київщині

«Може призвести до смерті»: лікарі розповіли, чим небезпечна сибірка, яку нещодавно виявили на Київщині
На одному із фермерських господарств на Київщині нещодавно у бактеріологічних дослідженнях кози виявлено збудник сибірки. Це небезпечна гостра інфекційна хвороба, людина інфікується нею від зараженої тварини, або ж через контакт зі шкурою та шерстю. За словами фахівців, захворювання має важкий перебіг і навіть призвести до летальних випадків, якщо не звертатись до лікаря.
— Встановлено захворювання на сибірку у кози, яка належала фермерському господарству Обухівського району. У господарстві утримується 337 голів кіз, підтверджено захворювання в однієї загиблої тварини. Наступного дня ми провели засідання Державної надзвичайної протиепізоотичної комісії, визначено загрозливу зону та затверджено відповідний план заходів щодо локалізації та ліквідації вогнища сибірки, — розповів «ФАКТАМ» заступник начальника управління — начальник відділу організації протиепізоотичних заходів управління здоров'я та благополуччя тварин Департаменту безпечності харчових продуктів, ветеринарної медицини та контролю у сфері органічного виробництва Держпродспоживслужби Олексій Клименок. — Медичною службою проведено медичні огляди працівників господарства та контактних осіб. Нових випадків захворювання не виявлено, всі тварини у фермерському господарстві клінічно здорові.
— Що це за захворювання — сибірка? Чи часто його фіксують в Україні? Чим воно небезпечне та до чого може призвести?
— Сибірка — гостре небезпечне інфекційне захворювання всіх видів сільськогосподарських, домашніх і диких тварин, а також людей. Основним джерелом є хворі тварини, які виділяють збудника в зовнішнє середовище з сечею, фекаліями, молоком та іншими виділеннями ще до того, як з’являються характерні клінічні ознаки: підвищена температура тіла, тимпанія, кольки, метеоризм, карбункули, інфаркти.
Особливою небезпекою збудника сибірки є те, що потрапивши в ґрунт, за сприятливих умов (температура зовнішнього середовища не нижче 12℃) він утворює спору. У споровій формі збудник може перебувати в ґрунті необмежений час, лишаючись життєдіяльним і зберігаючи патогенність. Ґрунт, заражений бацилами сибірки, тривалий час (70 і більше років) залишається збудником інфекції для сприйнятливих тварин або людини.
В Україні майже щорічно реєструються поодинокі випадки сибірки у тварин. Так, у 2022 році на поточну дату зареєстровано один випадок — Київська область (захворіла коза). У 2021 році був зареєстрований теж один випадок в Тернопільській області (захворів поні). Захворювання тварин на сибірку в переважній більшості призводить до загибелі тварини та створює значні ризики для інфікування збудником власників тварин або контактних осіб. Тому у разі появ ознак захворювання, потрібно негайно звернутися до лікаря ветеринарної медицини чи до територіального органу Держпродспоживслужби вашого регіону.
— Як саме сибірка передається людині та скільки часу проходить від контакту до зараження?
— Найбільш часто передається контактним шляхом, рідше аліментарним, повітряно-пиловим і трансмісивним. Контактний — через пошкоджену шкіру або слизові оболонки під час догляду за хворими тваринами: під час обробки туші, зняття шкури і поховання трупів загиблих тварин; із зараженим спорами сибірки ґрунтом під час земляних робіт. Аліментарний — через приготування і вживання їжі із м’яса, отриманого від хворих тварин. Аерогенний (повітряно-пиловий) — шляхом інгаляції спор. Трансмісивний — через укуси комах (ґедзів, мух, комарів).
Вхідними воротами збудника сибірки зазвичай є пошкоджена шкіра. У рідкісних випадках він попадає до організму через слизові оболонки дихальних шляхів і шлунково-кишкового тракту. Тривалість інкубаційного періоду коливається від декількох годин до 14 днів, частіше 2−3 дні. Захворювання може протікати в локалізованої (шкірної) або генералізованої (септичній) формах. У переважній більшості випадків (92−96%) у людей сибірка протікає в шкірній формі, пов’язаної з зараженнями через шкірні покриви при контакті з джерелами або факторами передачі інфекції.
Симптоми сибірки у людини — сильний головний біль; висока температура; загальне нездужання; карбункул зі швидким наростанням набряку та свербіж (за ураження шкіри); сильні колючі болі у грудях (у разі легеневої форми); задуха (у разі легеневої форми); діарея з домішками крові (у разі кишкової форми); ріжучі болі в животі (у разі кишкової форми); блювота з домішками крові (у разі кишкової форми). Якщо лікування розпочинається вчасно, хворі одужують. У рідкісних випадках перебіг хвороби ускладняється кишковою, легеневою або септичною формами, тоді захворювання має важкий перебіг і може призвести до смерті хворого. Тож за найменшої підозри на сибірку негайно зверніться до лікаря.
— Як відбувається лікування людини?
— Виключно в умовах стаціонару. Медична служба рекомендує не застосовувати антибіотики чи будь-які інші препарати для самолікування чи профілактики без консультації лікаря. За найменшої підозри на будь-яку форму зараження потрібна негайна госпіталізація.
— Як уникнути інфікування сибіркою?
— Не контактуйте з хворими або підозрілими у захворюванні на сибірку тваринами. Вакцинуйте сільськогосподарських тварин. Купуйте м’ясо та м’ясопродукти, молоко лише в місцях, де якість продуктів контролюють (не на стихійних ринках). Люди, які переробляють та реалізують м’ясо, м’ясопродукти чи будь-яку тваринницьку сировину, зобов’язані дотримуватися гігієнічних норм, щоб убезпечити себе та інших. Виконуйте ветеринарно-санітарні правила під час догляду за тваринами. Забій домашньої худоби — лише з дозволу ветеринарних спеціалістів. І обов'язково термінове звернення за медичною допомогою в разі прямого контакту з твариною з підтвердженим діагнозом сибірки та при наявності перших ознак захворювання.




